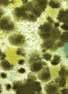

JAN/FEB 2023 BUSINESS INTELLIGENCE FOR THE RRC PROFESSIONAL RREC-070 + Improve your data security 12 + New approaches in a shifting market 22 + How to handle short sales 26 + Selling stigmatized properties 30 SET FOR SUCCESS Incoming RRC president Pam Ruggeroli, CRS, looks to lead the association into the future 18









 By Amelia Garza
By Shaila
By Regina Ludes
By Amelia Garza
By Shaila
By Regina Ludes



Residential Real Estate Council crs.com JAN/FEB 2023 1 Vol. 22, No. 1 FEATURES 18 22 26 30
18 Consistent and Persistent: Learn more about incoming 2023 president Pam Ruggeroli, CRS, and her journey through the real estate industry.
Cover
photo: Steven Meckler
22 Increase Engagement in a Shifting Market: As the real estate landscape changes, agents are taking new approaches to increase business.
26 The Recession-Era Experience: Experts who worked through The Great Recession of 2008 share how to handle tricky short-sale transactions.
By Michelle Huffman
30 Homes With a Troubled Past: Stigmatized properties can be difficult to market and sell. CRSs explain how to handle homes with unsavory histories.
Wunderlich
By Megan Craig
By Caroline Heller
EDITOR
Kimberly Cure kcure@crs.com 800.462.8841
ASSISTANT EDITOR
Amelia Garza agarza@crs.com

CONTRIBUTING WRITERS
Megan Craig Amelia Garza
Caroline Heller

Michelle Huffman
Regina Ludes
Shaila Wunderlich
2023 BOARD OF DIRECTORS
President
Pam Ruggeroli, CRS
President-Elect Tricia Nekota, CRS
First Vice President Vivian Macias, CRS Immediate Past President Holli Woodward, CRS Members Debra Beagle, CRS Bryan Hughes Addie Owens, CRS Kurt Thompson, CRS Tonya Thomsen, CRS Chief Executive Officer Jeff Hornberger Staff Liaison Patricia Stodolny
Advertising Inqueries
312.321.4410 bd@crs.com
The Residential Specialist is published for Certified Residential Specialists, general members and subscribers by the Residential Real Estate Council.
The magazine’s mission is: To be a superior educational resource for CRS Designees and members, providing the information and tools they need to be exceptionally successful in buying and selling residential real estate.
The Residential Specialist is published bimonthly by the Residential Real Estate Council, 430 North Michigan Ave., Suite 300, Chicago, IL 60611-4092. Periodicals postage paid at Chicago, IL, and additional mailing offices.
Change of address? Email requests to crshelp@crs.com, call Customer Service at 800.462.8841 or mail to RRC at the above address.

The Residential Specialist (USPS0021-699, ISSN 1539-7572) is distributed to members of the Council as part of their membership dues. Nonmembers may purchase subscriptions for $29.95 per year in the U.S., $44.95 in Canada and $89.95 in other international countries. All articles and paid advertising represent the opinions of the authors and advertisers, not the Council.

POSTMASTER: Please send address changes to: The Residential Specialist, c/o Residential Real Estate Council, 430 North Michigan Ave., 4 th Floor, Chicago, IL 60611-4092.
COPYRIGHT 2023 by the Residential Real Estate Council. All rights reserved. Printed in U.S.A.
crs.com
JAN/FEB 2023 2 iStock.com/ CONTENTS Vol. 22, No. 1 12
7 48
9
PUBLICATION MANAGEMENT
Publishing Manager
4 Aerial
5 Getting
6 Real
Market Pulse 8 Personal
9 Engage
agents
www.glcdelivers.com
Scott Mason Art Director Ivette Cortes
View Pam Ruggeroli, CRS
to Know: Q&A with new RRC CEO Jeff Hornberger.
Talk Recap: What you missed from recent RRC podcast episodes.
Perspective: Ana-Seydi Lopez, CRS, AS Propiedades, San Jose, Costa Rica
With E-News: Advice on how
can strengthen their e-newsletter offerings for clients.
12 Data Security
Cybercrime:
in an Age of Rising
Keep your data and information safe from bad actors.
16 Smart
34 Market Values Insights
Specialized Knowledge 36 Council Classroom: How to build your brand through authenticity. 38 Marketing Matters:
top of mind with clients
Designation Nation 40 Your Own Council: RRC news and updates. 42 Ask a CRS: Advice from the country’s top agents. 44 RRC Connect: Expand your network. 46 Balancing Act: The benefits of setting aside time to read. 48 Taste of
Living: What agents should focus on when seasonal market slowdowns result in less volume.
from industry data.
Staying
in 2023.
RRC: A recipe shared by an RRC member.










ATLANTA, GA FEBRUARY 8-10, 2023 Visit CRS.COM/SAB for more information and choose one of three available registration options! Use code SAB7 to save 15% OFF registration by 1/31/23 .
Because I love giving back, it’s always been important to me that I stay involved with the Council and RRC leadership.”
Inspiring Our Members

It’s an absolute honor and privilege to step into my role as president of the Residential Real Estate Council. I’m excited for the upcoming year. Our entire leadership team and Board of Directors were all member-elected, which means the world to me, and I know it means the world to all of them, too. We are passionate about the CRS Designation and the Council—we want our members to have what they need to succeed. We are here to listen and help. The theme of the Council’s year is “Inspire.” I chose this theme because I believe every single one of us can make

a positive impact on someone else’s life. I wouldn’t be sitting in this seat today if it weren’t for the people who encouraged and inspired me to do more, be more and have more. I know that everyone who’s currently in a leadership role got there because someone else asked them to be there and encouraged and inspired them to do more. I want to impress upon our members that they can have that same positive impact on future leaders and future members.
Because I love giving back, it’s always been important I stay involved with the Council and RRC leadership. I started volunteering for the Council at the state level, serving as treasurer for the Arizona RRC in 2007, where I eventually worked my way up to holding the president’s role in 2009. From there, I served as the regional vice president for North Carolina, South Carolina and Tennessee from 2012–2015. I encourage all of you to get involved, whether it be with your local, state or national leadership. Getting involved made a huge impact on not only me, but also my profession and the success of my business.
I know we’re facing challenging times, but that’s when the cream rises to the top. We are CRSs. We represent a proven path to success. It’s our job to educate and inform the public and the consumer— our clients—about what’s happening in the market and what they can do to be successful. This is where we really start to shine. I see this year as a great opportunity to grow, reach out to our clients, help them understand the market and help them get to the next level, wherever that may be for them.
The Residential Specialist trsmag.com JAN/FEB 2023 4
Aerial View From the desk of Pam Ruggeroli, CRS, 2023 RRC President
Photo: Steven Meckler
Getting to Know
Q&A with the CEO
Meet RRC’s New CEO, Jeff Hornberger

What drew you to the CEO position at RRC?
I’ve known RRC for more than 20 years, and it’s been an organization that has crossed my path throughout my career. It’s an honor to lead this organization after observing it from the sidelines for so many years. In my capacity at NAR Global, no matter where we traveled, countries would always request courses leading to the CRS Designation. It truly has a reputation as the gold standard in residential real estate, and the brand power has always been there. In my most recent position at the Women’s Council, each time we did member surveys, RRC was the top crossover organization. So the memberships are similar, and I’ve always studied how RRC does things. It’s an outstanding organization with great potential, world-class education, and enthusiastic and passionate members. Those are just some of the reasons I’ve been drawn to the organization for more than 20 years throughout my career.
What about the real estate industry do you like the most?
I used to sell barcoding machinery that placed expiration dates on product packaging in factory lines. As much as I tried, I found it difficult to get interested. The real estate industry, however, is so different. No matter where you go in the world, real estate is the major economic driver and is an industry that is on everyone’s minds. From entertainment (TV shows) to fulfilling dreams, it’s an industry that everyone relates to. The industry is interesting, and the learning never ends.
What inspires you?
The members! One of the reasons I’ve remained in the real estate association world for so long is the members’ passion, time and energy that they dedicate to organized real estate. It fuels my energy to work collaboratively to get things done and be good stewards of an association.
REALTORS® are professionals who are down-to-earth people, probably because every day in their work they cross paths with people from all walks of life. As professionals, they have a front-row seat to it all and have an understanding of what’s happening in the real world.
What is the best leadership advice you’ve received?
The 1990 national president of NAR, Norm Flynn, was a great mentor and friend and taught me
everything I’ve known in my leadership journey. He was a believer in the concept and mantra of “servant leadership.” He felt that associations were unique businesses because staff’s job in leading was not just be the “sage on the stage” but also be the “guide on the side,” meaning you have to work in partnership with volunteer leadership to achieve success. I observed his collaborative style and approach throughout the years. Sadly, he passed away in 2021, but knowing him and having his leadership advice and mentorship over so many years was a true gift. He was never too busy to take a call or help me solve a problem.
What is your hope for the future of the Council?
Our vision is to be the premier business organization for REALTORS® and international real estate professionals. This means, if we are the top 3% of agents in the U.S., we should be around 48,000 designees—and the membership and the value it offers should make RRC the go-to organization for their business. What we offer should provide valued differentiation.
What do you like to do in your free time?
I like to do long runs in the forest preserve, and if there isn’t snow on the ground, I do it throughout the year. It’s great exercise and clears the mind. Family travels are always a great way to connect and spend time. With our two daughters in college, any time we spend together as a family is precious. At home, my wife and I are new empty nesters, which means our spoiledrotten Goldendoodle, Chloe, gets all of the attention while we attempt to find a good TV series to binge watch. (Suggestions are always welcome.)
iStock.com/ Residential Real Estate
crs.com JAN/FEB 2023 5
Council
Jeff Hornberger
Have you been listening to RRC’s “Real Estate Real Talk” podcast? If you’re late to the party or forgot to tune in, here’s a peek of what our expert CRS hosts have been discussing in recent episodes.
What You Missed on Real Estate Real Talk

Episode 17
“What Happened to Starter Homes?” Maybe a better name instead of starter home is chapter home, because we all enter new chapters of our lives, and every time a new chapter [begins], it’s a [fresh] start. You have that chapter as a first-time homebuyer when you’re perhaps single, like I was. Then your [next] chapter is when you have children. And then when those children leave the home, it’s a different chapter. Then sometimes we have live-in girlfriends or boyfriends, and that breakup happens.
Or you start working remotely. Those are different chapters … and we have to have price points accessible for everyone across that board.
Episode 19
“Preparing for and Thriving in 2023”
I always knew at some point, the market was going to shift, and partly why I haven’t felt as much of that shift so far is because I’m still working my plan every single day. It’s so important that you set that plan and you work it every single day, no matter how you’re feeling, no matter what you’re doing, what’s going on in your life. You have to keep working that plan.
Brian Copeland, CRS


Episode 18
“Millennials Reshaping the Homebuying Process”
 Alex Milshteyn, CRS
Alex Milshteyn, CRS
Episode 20
Listen to new episodes and access the entire archive of “Real Estate Real Talk” episodes at CRS.com/realtalk or wherever your favorite podcasts are found.
I do think that there is a feeling from some of the older generations that millennials have this sense of entitlement. However, to bring a positive spin to that word, I think that everyone is entitled to want to own a house and entitled to find ways to do it. And I don’t just say that because that’s our livelihood—I say that because it truly is the right thing … If we have an affordability problem, which we do—if we have an inventory problem, which we do—we need to start looking proactively for solutions, not just for ourselves and not just for the next generation, but the one after that and the one after that.
Maura Neill, CRS
“The Approach to Pricing Today”
What we’ve done in our market is have panels with five different appraisers—and the room is full. If you haven’t had something like that in your market, talk to your Association of REALTORS® and ask them to put a panel together with four or five appraisers in your area for an afternoon lunch and learn. I guarantee you they will be willing to come in there and sit down, and it’s going to be some of the best education that you’ll get.
Holli Woodward, CRS
The Residential Specialist trsmag.com iStock.com/bsd555/Anastasia Shafranova Real
Recap
podcast hosts JAN/FEB 2023 6
Talk
Thoughts and opinions from our
PERSONAL PERSPECTIVE
PAGE 8
DIGITAL MARKETING
How to turn mundane e-newsletters into amazing marketing materials to help your business.
PAGE 9
CYBERSECURITY
Threats to data security are lurking around every corner, and CRSs need to be ready.
PAGE 12
SMART LIVING
Even when business is slow, there are many ways to stay engaged and grow professionally.
PAGE 16

Residential Real Estate Council crs.com JAN/FEB 2023 7
JAN/FEB 2023 7
Photo:
Carlos Alfonso
Quesada Sibaja
Ana-Seydi Lopez, CRS, hikes a Solaris luxury property in her home country of Costa Rica.
Market
IDEAS
Pulse TRENDING HEADLINES AND
Ana-Seydi Lopez, CRS
AS Propiedades, San Jose, Costa Rica
How did you get involved in real estate?
I am from Costa Rica, which is a small country of only 5 million people, so I don’t have just a country, I have a region.”
I started because I wanted to be a professional, but I also wanted to be a mother. When I had my first child, I was working at A.C. Nielsen in market research. When I left my job there, I wanted to be sure I could have enough time for my kids. Someone suggested that I do real estate.
At the beginning, I thought I had too much knowledge and experience to do only real estate, but I took a course from the Costa Rican Real Estate Association. Awhile later, my mother needed to sell her house, so I put my very first sign there, and that was the first house I sold. Then, I started getting calls from school friends who wanted me to work with them. That’s how I started in the business 14 years ago.
be licensed. But I always try to be very professional. For that reason, I have been active in our real estate association here. I’ve been on the association board of directors as well as president.
I also joined NAR, where I met Fernando García Erviti at an annual convention. About five years ago, when I learned that he was conducting REAP courses (Real Estate Advanced Practices) in Spanish, I decided to take the course, which is required for the CRS Designation. So I went to Miami to take the course and applied for the designation. I also took the Train the Trainers course to become a CRS instructor. Since 2021, I have been an instructor for Central America and the Dominican Republic.
a lot of people interested in the training because it helps agents. We are the first to become better and improve our businesses. Erviti started to come to Latin America, and due to demand, he has started CRS LatAm. In Latin America, we have different directors in charge of each country. I am from Costa Rica, which is a small country of only 5 million people, so I don’t have just a country, I have a region.
What is the Costa Rican real estate market like?
and we have a stable government with democratic elections and no army. People are looking for that kind of security when they come to Costa Rica to invest.
What do you do to have fun?
Ana-Seydi Lopez, CRS, achieved the CRS Designation in 2018. She can be reached at as@ aspropiedades.com, or +506 8888-6611
How did you become a CRS?
In Costa Rica, we don’t have real estate law and you don’t have to
How are you active with RRC?
After offering that course in Miami, it started a big movement in Latin America. We had
I was invited to a REALTORS ® convention in Miami, and my presentation was built on the idea that Costa Rica is more than beaches. We have commercial real estate, second homes and residential. I work in residential in the central valley in the capital. Our reputation is great for businesses, including many international companies. The economy is good,
I’m an empty nester now. My son, André, is a pilot and lives in Oklahoma, and my daughter, Louisianne, is studying in Netherlands. She always says, “Oh, Mom, you are so boring,” because I love real estate. I love to read real estate books and watch real estate reality shows on TV. Now that I have some free time, I’m putting a lot of energy into RRC because I trust in the CRS training and I believe that we can make a positive impact in the lives of REALTORS® and their businesses.
Beyond that, I love to dance to Latin American music. I swim and do Zumba twice a week. And I also love to hike. We have some nice places for hiking, so I try to hike twice a month in the country.
The Residential Specialist trsmag.com JAN/FEB 2023 8 Personal Perspective Profiles of people to watch MARKET PULSE
Engage With E-News
By Megan Craig
REALTORS® know they need to stay top-of-mind to be competitive in the industry. But the marketing tactics you’ve used for years may not be doing the trick anymore.
Looking for another way to subtly market yourself all year long? E-newsletters offer a low-pressure, high-impact way to connect with clients.

Jen Ward, CRS, REALTOR® at Cummings & Co. Realtors in Lutherville, Maryland, started sending e-newsletters more than 10 years ago. She wanted another way to remind clients of her expertise and
dedication to their home purchase needs and beyond, and e-marketing appealed to her because of its simplicity.
Ward drops her e-newsletter right in the middle of the month, every month. The newsletters include a mix of tips for homeowners, action items for the month and some more personalized, funny, “slightly silly” stuff (like song lyrics or a meme) to keep people engaged.
“It’s just another touch point, so that I’m in touch with my people at least once a month. Whether they read it or they don’t, I’m at least in their inbox,” she says.
Residential Real Estate Council crs.com JAN/FEB 2023 9 iStock.com/juststock/Illustrator de la Monde
your e-news strategy Digital Marketing
Strengthen
E-newsletters offer a low-pressure, high-impact way to connect with clients.
Consistent contact
REALTOR® Kate Johnston, CRS, of Key Realty in Redmond, Washington, had long mailed out newsletters but added a digital version to her marketing repertoire around 2017. She aims for consistency: Her newsletters always contain some real estate news, information on places to go and things to do in the community, and a local business spotlight.
In addition to acting as another point of contact for her clients, Johnston says she loves that sending an e-newsletter offers her real-time data on how many and which clients see her content.
“You can see the open rate and the instant response,” she says.
She uses that data to better plan for distribution. For example, she doesn’t send her e-newsletter on Monday mornings because people’s inboxes are already flooded from the weekend. Analysis of the data told her aiming for the end of the week meant a better email open rate.
Johnston is also able to use that information to keep her contact list updated.
“Did I get a bounce back? Did their email change or is it typed in the database wrong?” she says. “I’m able to be more selective, to keep the list really tight.”
Maintaining a solid contact list and being able to consistently communicate with that list is important when sending e-newsletters, Ward says. She uses her CRM, which helps her stay organized and designate specific times for the e-newsletters to be sent.
But being consistent is different from being boring, Ward warns. Be sure you’re changing the advice and the types of articles from month to month, year to year, so your clients don’t start to ignore your emails.
“I always put in something kind of fun, and that’s when people start looking at it,” she says.
Designing for impact
Content isn’t the only important part of a newsletter; you also need to consider the design and layout of the information.
Ward has used several programs over the years to give her newsletters a polished look:
f Mass email programs like Constant Contact and Mailchimp allow you to design a newsletter within those programs before mailing out to your list.
f An online hosting service like Issuu will allow you to create and preserve a digital publication and offers newsletter creation software.
f Many CRMs come with newsletter creation components.
Johnston takes it one step further: She pays a designer to make her newsletters shine.
The Residential Specialist trsmag.com JAN/FEB 2023 10 MARKET PULSE iStock.com/vectorjuice
Digital Marketing Strengthen your e-news strategy
Your newsletter and marketing should be an extension of who you are so you can ‘connect’ with the people you know.”
—Jen Ward, CRS
Know your audience— and help them get to know you
It helps to have an audience, Ward knows, since that allows her to curate the messages and stories in her e-newsletters.
“I know my people—it’s going out to my database—so I like to find articles that will interest them,” she says. “But Grab your reader’s attention
Ward, used to send out her monthly e-newsletters with basic, boring subject lines—“What’s Happening in Baltimore Real Estate,” for example—but realized that wasn’t enticing anyone on her list to actually open the emails.
Basic data from her CRM showed an open rate around 10%, “and that just wasn’t going to work,” she says.
Now she uses song lyrics so her subject line will stick out in the long list of emails her clients receive every month. Sometimes it’s a throwback. Sometimes it’s from a contemporary artist, like Harry Styles or Nelly. For July, she used “Hot in Herre;” in September, she used the iconic song “September” by Earth, Wind & Fire.
As soon as she started adding personality to her e-newsletter subject lines, her open rate jumped from 10% to about 40%.
it’s also a chance for me to connect through my personality.”
Ward is a professional agent, but she’s also fun-loving, she says, and her clients know (and love) that about her. That’s why including emojis and song lyrics in between reminders to clean their gutters works for her. She also includes a personal message, reminding people that she’s always around to talk about the market or answer real estate-related questions.
Johnston aims to give her clients “sticky content”—tips, tools, advice and articles that will stick with them long after they’ve opened her e-newsletter.
“My goal is that when I stop at somebody’s house, they still have that guide I emailed out hanging on their refrigerator,” she says. “That’s how I know it worked; that’s how I know I’ll be top of mind and memorable.”
Take advantage of the monthly, CRS-branded newsletter, “Your Home,” created for CRSs to share with clients. Download today at CRS.com/ resources/yourhome-newsletter
“It sparks something, and it just seems to get people’s attention,” she says. “They’re like, ‘Jen’s sending another crazy email; I want to take a look at that,’ which is fantastic. Your newsletter and marketing should be an extension of who you are, so you can ‘connect’ with the people you know.”
JAN/FEB 2023 11
Residential Real Estate Council crs.com
There were more than 11,000 victims of real estate cybercrime in 2021, resulting in total losses of $ 350.3 million .

Total losses increased more than $ 135 million in just one year.
Source: FBI’s Internet Crime Complaint Center
The Residential Specialist trsmag.com JAN/FEB 2023 12 iStock.com/ MARKET PULSE
Cybersecurity Keeping private information safe
Data Security in an Age of Rising Cybercrime

 By Caroline Heller
By Caroline Heller
Cybercrimes are on the rise— especially crimes affecting real estate transactions and data privacy. According to the FBI’s Internet Crime Complaint Center, there were more than 11,000 victims of real estate cybercrime in 2021, resulting in total losses of $350.3 million. Even more shocking was that total losses increased more than $135 million in just one year. As more elements of real estate transactions move online and more technologies are being used to assist agents, a focus on data privacy and cybersecurity is necessary. Here we’ll examine how agents can keep their and their clients’ data safe.
Know how dangerous regular email can be Confidential information should never come through email. Use encrypted email or a document-sharing program to share this kind of sensitive information. You should also take extra precautions to ensure your passwords are safe. Sandy Workman, CRS, broker at Coldwell Banker in Bradley, Illinois, always makes sure her passwords are complex and different for each program or account she uses. “I’ll mix up names, numbers and special characters so that my passwords are random,” Workman says. “The more difficult you make it, the safer it is.” She also uses two-factor authentication to ensure only she has access to her accounts.
Residential Real Estate Council crs.com JAN/FEB 2023 13 iStock.com/D-Keine/Just_Super/fonikum
Cyber attacks occur daily. Mitigate the risks by attending the classroom course “Protecting Your Business and Your Clients” at CRS.com
Don’t leave it open or out Don’t leave your computer open or be signed into accounts when you’re not around. “I’ll walk into the office, and agents have their MLS up or their email, and they don’t sign out of it,” Workman says. “Some will even leave for the day with a computer still logged into.” Workman says she taught her kids an important lesson when they left a computer open with their Facebook account still logged into.
“I got on and posted ‘My mommy is the greatest mommy in the world,’” Workman says. “They learned quickly to log out of applications or close their laptop.”
The same thing goes for leaving important documents at fax machines or out on desks at the office. “I’ve seen contracts or preapproval letters left on fax machines for several days,” Workman says. “Those have all kinds of information that should be kept confidential.”
MOST COMMON TYPES OF CYBERCRIME THAT AFFECT REALTORS®
Phishing is the attempt to obtain personal or confidential information, often by using a spoofed email address. A spoofed email address is a forged email sender address that appears to be from a trusted or familiar source. Often the messages will have links to malware or attempt to convince the recipient to provide confidential information, like passwords, name, address, Social Security numbers, etc. Phishing attempts can also be done through phone calls and text messages.
Malware is short for “malicious software,” which is a program installed on your computer without your consent, usually causing harm. Some common types of malware are keyloggers, spyware, viruses, tracking cookies, ransomware and adware.

Wire fraud is when cybercriminals use hacked or forged email accounts to send fraudulent wire instructions so that the money is sent to the criminal’s bank account.
Rory Dubin, CRS, a broker manager at United Real Estate Gallery in Jacksonville, Florida, includes an important wire fraud alert in his email signature to inform clients of this dangerous crime that has been increasing over the past few years. The alert advises buyers and sellers “not to wire any funds without personally speaking with the intended recipient of the wire to confirm the routing number and the account number.”
The Residential Specialist trsmag.com JAN/FEB 2023 14 MARKET PULSE iStock.com/batuhan toker/agungsptr
Cybersecurity Keeping private information safe
Limit details on social media
You should be wary about posting information on social media because those accounts are easy to hack and are also monitored by people wanting to send fraudulent wire information. “Even on social media I’d be careful about broadcasting specific financial information or prices,” says Rory Dubin, CRS, a broker manager at United Real Estate Gallery in Jacksonville, Florida. “It’s fine to say a transaction is closing, but when you start getting specific about dollar amounts, especially high dollar amounts, it’s going to attract the interest of people you don’t want.”
MARKET MOMENT
Where Are Homeowners Sticking Around the Longest?
Homeowners will likely have to decide on whether to move at least once in their life. But which markets see residents staying in their homes for longer periods, and which see the most movement?

Educate
clients about wire fraud and sending sensitive documents


You should also teach clients about the dangers of wire fraud. “I tell my clients from day one, the minute I meet them, about wire fraud,” Workman says. She gives them a wire fraud document to sign that instructs them not to give financial information without anyone’s knowledge. Dubin also advises his clients against sending personal financial information to him directly. “I typically tell the buyer to do all the financial pieces with their lender,” says Dubin. “The agent doesn’t really need that information; it’s really between them and their lender.”
To answer these questions, Realtor.com looked at sale record data from CoreLogic, a real estate sale data provider. The data, collected between January 2001 and August 2022, focused “on the median number of months that passed between the most recent home sale and the previous time it changed hands, for the largest U.S. metropolitan areas.” The research revealed the metros with the longest and shortest times between sales. Here are the top five in each category:
For more details on Realtor.com’s findings, visit bit.ly/ homeownersstaying-put
Metros With Longest Time Between Sales
McAllen, TX New York, NY Baltimore, MD Miami, FL Washington, D.C
10 years, 3 months 9 years, 5 months 9 years, 3 months 8 years, 8 months 8 years, 4 months
Metros With Shortest Time Between Sales

1 2 3 3 5 Tied
Colorado Springs, CO
Greenville, SC Indianapolis, IN Knoxville, TN Spokane, WA
4 years, 9 months 5 years 5 years, 1 month 5 years, 1 month 5 years, 4 months
Residential Real Estate Council crs.com JAN/FEB 2023 15 iStock.com/Andreus/dem10/Elena_Garder
1 2 3 4 5
Learn how to stay active and get more involved in your community by attending the webinar “Locally Grown: State and Local Involvement” at CRS.com/ webinars
Keeping It Moving in the Slower Seasons
Winter has traditionally been slower for the real estate industry. If that is the case for you this season, it doesn’t mean you have to hit the brakes on your

business. There are many opportunities to sell in the winter, and it’s a great time to take stock of your business and do a little work to prepare for the peak months ahead.
Sell in the winter
The winter is not a total dead period when it comes to real estate sales, and depending on where you live, your business may never slow down. But there are always people moving throughout all seasons and who need to buy and sell. There are some clear advantages to selling in winter: less competition, initiative-taking buyers and the ability to highlight the winter side of your home. It all comes down to determining the buyer’s or seller’s motivation and knowing what to say to ease any hesitations.
Build the Rolodex
A slowdown in business means you can focus more on your real estate networking and marketing efforts. You want to get as many leads as possible into your pipeline so when spring comes, you are ready to jump into action. Consider attending more community events and business luncheons, and setting up more coffee dates with new friends—or a new agent you’ve met. Search for volunteer opportunities in the area where you could meet new people. Whatever you do, follow up with any new contacts you meet.
Bring fresh skills to life
It can be difficult to find time to educate yourself when things are busy. But as a CRS, there is a responsibility and duty to maintain, develop and grow skills and knowledge to stay with the times. Winter is a great season to sharpen overall skills, especially after the last few years of volatility. This means taking advantage of training, improving your phone skills, working on your sales scripts or presentations and learning innovative marketing techniques. Excellent resources are never more than a few clicks away—you just need to find the time to sit down and utilize them.
Research
Another wonderful way to utilize free time during the industry’s off-season is by conducting research of trends in your market and branching out into new fields or niches. Having a better understanding of your market means you can find niches or angles to help you improve your outreach. What demographic has been migrating to your area? What price range sold the most in 2022? Consider getting specialized in new areas to build and attract new clients in that space.
The winter season can be demotivating. But agents can fight back negative feelings by staying busy and working their business in new ways, preparing for when things pick up again—because, it inevitably will.
The Residential Specialist trsmag.com JAN/FEB 2023 16 Smart Living Tactics for professional growth MARKET PULSE iStock.com/Ольга Симонова/-VICTOR-
A podcast produced by RRC
Industry news made simple.
The Real Estate Real Talk podcast is hosted by leading agents that can help you cut through the noise and grow your knowledge and expertise.



www.crs.com/realtalk
Consistent Persistent and

The Residential Specialist trsmag.com JAN/FEB 2023 18
By Amelia Garza
Real estate was always in Pam Ruggeroli’s DNA—but that didn’t mean she entered this industry without hesitation.

“My mother was a REALTOR® for 30 years in Las Vegas, Nevada, where I grew up, and I swore I would never be a REALTOR ®,” says Ruggeroli. For 15 years, she had a successful career as a dental hygienist, until she suffered an injury to her hand. As a single mother going through a divorce, she had to find a new path that would allow her to be there for her children.
In 2001, while selling candy bars for her daughter’s cheer team, which she coached, Ruggeroli met a broker who reintroduced her to the real estate industry.
“He handed me his business card and said, ‘Call me on Monday. Let me see how I can help.” After several months of friendship, he sat her down and said, “You’re going to real estate school,” and even paid for her classes. She’s been a REALTOR® ever since.
“In the beginning, real estate was hard,” says Ruggeroli. “I thought, ‘Oh my gosh, I’m going to fail something for the first time in my life!’ It’s not the easiest business to get started in, but it is the most rewarding business if you are consistent and persistent.”
Over the past 20 years, what skills have served you the most in your business? With real estate, my favorite part is helping people, especially first-time homebuyers. It’s such an exciting and scary experience for them, and [it’s important to] have a professional who can guide them through the process and basically take them by the hand and show them step by step how to get where they want to be and fulfill their dream of homeownership.
It’s been a tumultuous market. How can RRC continue to serve its members best in changing times, and what do you see happening in the market in 2023?
I wish I had a crystal ball ... I see the market normalizing right now. What we experienced for the past two
Top: Pam Ruggeroli, CRS, (left) poses with her mother. Bottom: Pam's mother and colleague featured in a newspaper article in Las Vegas, Nevada.


Residential Real Estate Council crs.com JAN/FEB 2023 19
Photo: Steven Meckler; iStock.com/appleuzr
f Ruggeroli’s family (L–R) : Dylan (son), Casey and Lauren Johansen (son-inlaw and daughter), Jeano Savard (fiancé), Ruggeroli , Wyatt and Haegan Ruggeroli (grandsons) and Chance (son)

Ruggeroli’s Checklist
When Ruggeroli is not at work, you can find her:
f Spending time with friends and family
f Golfing for charity
f Completing a puzzle
f Tidying up her home and office
f Catching a flight
f Watching football
f Watching murder mystery shows
years is not normal. To have an interest rate below 3% is not normal. To have only a few hundred homes on the market in any given market is not normal. So I feel like we are stabilizing. And in 2023, I think we’re going to see a flat, even keel. It’s our job as REALTORS® to educate our sellers and buyers. Times have changed, and we need to be willing to give to these buyers to help them. And then letting them know that, yes, interest rates are higher, but you have two options: You can either pay yourself or you can pay somebody else. If you’re paying rent, you’re paying somebody else’s mortgage, and they’re the ones that are making all the money. Or you can invest in yourself, pay your own mortgage and have potential equity down the road. It’s all up to us and the lenders to educate our buyers and sellers.
Is there any advice you’d give to new agents getting started in today’s market?
Be persistent and consistent. Don’t give up. That’s all you can do. It took me time, but it’s all about building relationships. I think that’s what has made my career as successful as it is. If I just did it and stopped, did it and stopped, I probably wouldn’t be where I am today.
What is the best business advice you’ve received in your career?
Delegate is the No. 1 thing. Also, my biggest thing I teach new agents when I’m
mentoring and training them is if you take care of the people, the money will come. If you’re chasing the money and you’re not doing the right thing, it’s not going to work out. If you focus on what’s in the best interest of your clients, then everything else will work out.
What are some ways you stay active in your community and give back?
From the time I was young, I was involved in different charities and fundraising. I always say, if I had a dime for every dollar I raised, I’d be a multi-millionaire. Since 2016, my primary charity of choice is Care Fund. It provides mortgage and rent assistance to families with critically ill children. We have our big fundraiser every year in October. When a child is diagnosed with a critical illness or has a critical injury, these families are devastated. Many don’t have a lot of money to begin with—but then suddenly, one of the parents must take time off work to take that child to the hospital or doctor’s appointments, the prescription medications are through the roof and the hospital bills are crazy. The goal is to help these families have a roof over their heads. One of our mottos is, “Keeping families safe at home.” We believe no parent should have to choose between going to work and caring for their child. It’s not just all the big things we can do, but it’s the little things.
The Residential Specialist trsmag.com JAN/FEB 2023 20
How has your family helped shape your career?

My mom and dad always encouraged me that I could be, do or have anything I wanted if I was willing to work hard enough for it. My family has always been there to support me. My mom and dad are no longer around, unfortunately.

My kids give me a hard time, saying that they grew up with me on the phone constantly and were craving my attention, but they’re very supportive of me. It’s funny because now I see them kind of doing some of the things that I learned from my mom. My daughter is in association management and is involved in different charities, so I see them learning to give back. I learned it from my mom, and they learned it from me. My partner, Jeano, who I’ve been with for more than 20 years, is a REALTOR® as well, and he shows houses for me, does home inspections, puts on lock boxes, you name it. He’ll do anything to help me— especially when I’m traveling for RRC.
What or who would you say is your biggest motivator
in your personal life?
I work as hard as I do because, honestly, I want to take care of people. If I look back to 2001 when I became a REALTOR ®, my “why” was my children. I wanted to buy them a house so they could have their own home to live in, and I did that. Then I worked hard to make sure they had everything they needed while they were going to school. Now, I help them any way I can as adults. I always say, work hard so you can play harder. I love working hard so I can spend time with my grandchildren in Texas.
at RRC?
When I ran my campaign for first vice president, my slogan was “Members first.” I want to make sure our members have what they want or need to help them be successful. I’m in this for our members—for the success of our Council and no other reason. I want RRC to continue to be the best education and business development provider for all REALTORS®. I think every REALTOR® should be a CRS, and anything I can do to help nonmembers understand the value of
being a CRS designee, I’m here to help with that as well.
Your theme for next year is “Inspire.” Tell us about the meaning behind that word for you.
I attended Kenny Parcell’s leadership summit in Chicago last August, and it was very inspirational. I got to thinking: How did I get where I am today? And it was because of the people I was surrounded by that inspired me—my parents, the broker who became my friend and encouraged me to go to real estate school, I can go on and on.
Every single one of us, whether it be staff, current members or future members, we all have the ability to make a difference in somebody else’s life by inspiring them. I know for a fact I wouldn’t be where I am today had people not seen something in me that I didn’t see in myself. I’m proud, thankful and grateful for all the positive, inspirational influences I’ve had in my life over the years.
Residential Real Estate Council crs.com JAN/FEB 2023 21
What motivates you to be a successful leader
Top: Ruggeroli (second from right) at a Care Fund charity event in October 2022. Left: Ruggeroli at a charity golf tournament
INCREASE ENG IN A SHIFTING MARKET
By Michelle Huffman
Over the summer in 2022, as the Federal Reserve shifted interest rates upward to battle inflation, the housing market responded. Once dominated by limited inventory, bidding wars and homes selling way above asking price, the market is now marked by growing inventory, shrinking buyer ranks and homes sitting on the market until sellers offer price reductions.
“In
market, buyers have suddenly lost 10% to 20% of their buying power,” says Donna Jones Craig, CRS, broker with Jim Maloof Realtor in the Peoria, Illinois area. “The market has absolutely slowed down.”
The sudden shift has led many CRSs to scrutinize their lead generation strategies and take a deeper look at what’s working and what’s not, and what they think will be most effective in the future.
Here are 5 strategies CRSs are deploying to generate leads amid market changes.
The Residential Specialist trsmag.com JAN/FEB 2023 22 iStock.com/
Without a doubt, the housing market has changed this past year.
my
“In my market, buyers have suddenly lost 10 % to 20 % of their buying power.”
—Donna Jones Craig, CRS
AGEMENT
1START A “GOLDEN LETTER” CAMPAIGN

When he had buyers lined up but no inventory to sell them, Sven Andersen, CRS, CEO of Andersen Group Realty in Winchester, Massachusetts, started a “Golden Letter” campaign. This involves delivering a hand-addressed yellow envelope with a handsigned letter informing the homeowner that he has buyers interested in their home. They call a specific number assigned to the campaign to get in touch with Andersen’s team.
While initially designed to drum up listings, the campaign has recently found an equilibrium: More sellers are reaching out because they want to capitalize on high home prices and Andersen is starting to reduce his backlog of 127 signed buyer clients.
“We are really matchmakers here,” he says. “It’s a win-win for a lot of different people and it’s just about the right time for it.”
When he does wind up representing buyer and seller—a dual agency relationship (highlighted in the November/December 2022 issue of The Residential Specialist)—he has both parties sign a document recognizing the situation to avoid potential problems that may arise.
Residential Real Estate Council crs.com JAN/FEB 2023 23 iStock.com/Jiri Studnicky/venakr/bsd555
STRATEGICALLY DEPLOY YOUR MARKET DATA

Because the market is changing, potential buyers and sellers have renewed interest in what’s happening, several agents say. And because the market isn’t predictable, they want to keep receiving this information.
This provides agents with an opening to establish new leads and develop a relationship over time by staying in touch with market data.
Jones Craig uses Moxi, but says there are plenty of similar programs that pull up market information like prices
3 HOST BUSINESS NETWORKING EVENTS

Kina Knisley, CRS, of TeamK2 with Keller Williams Honolulu in Hawaii, has restarted the elite networking events she was running pre-pandemic. At that time, they produced a database of about 1,200 people she was able to tap during lockdown.
These branded informal networking events connect businesspeople in her community. She is in the process of experimenting with locations, having tried a brewery that attracted a younger crowd, and then a yacht club that brought in a diverse group of older business owners.
To connect with these potential clients, she mingles, collects business cards for drawings and has even started using
and days on market for individual neighborhoods in an easy-to-read report. These reports can then be shared with potential clients.
Marty Haines, CRS, broker associate with the RE/MAX Alliance Group in popular retirement community Venice, Florida, takes it a step further.
“I recently did a mini video addressed to people who bought a home a year or two ago and told them if they’re interested in knowing the value of their homes now, reach out and I’ll pop it in the mail,” she says.
her phone to do a 45-second interview of about five people each night introducing her audience to her interviewee’s business.
She’s expanding her networking offering with a monthly lunch to trade referrals and hear a business coach speak on different topics.
The Residential Specialist trsmag.com JAN/FEB 2023 24 iStock.com/ARTQU/Anchiy/Jiri
Studnicky
2
REINVEST IN YOUR REFERRAL NETWORK
Because Haines’ business is primarily built on referrals, she is doubling down on her referral sources: Past clients and other REALTORS® whose clients are interested in retiring to Florida.
“We were in the feeding frenzy for two years and there’s been very little time to build relationships with anyone,” Haines says. “Now it’s time to go back to basics.”
She’s executing this strategy two ways. First, making phone calls, writing letters and doing pop bys.
Haines likes to have fun with her pop bys. She recently included a bag of pretzels with cheese dip that said, “Don’t get twisted in your next transition.”
Second, she’s heading out to real estate seminars, conferences and industry events to get in front of her REALTOR® referral partners.
Similarly, Jones Craig is doubling down on her sphere of influence. “Everybody knows three REALTORS ® if not five, so go back to your past clients, friends, family, community organizations or kids’ activities and remind them who you are and that you’re available to help.”
5HOST MEMORABLE CLIENT APPRECIATION EVENTS
Client appreciation events have also come back in a big way.
“Events have some of the best return on investment for us,” Andersen says.

The last event he hosted was at an outdoor farm space that has bumper boats, a driving range, batting cages, mini golf, a petting zoo and more. Giving people the opportunity to have a unique experience or make memories with their families are especially popular.

“People come to these events and just enjoy the day. And afterward, they want to support and help us with referrals,” he says.
While the current market shift has caused many buyers and sellers to pump the brakes, Jones Craig reminds herself and her team, Move Smart Group, that people’s lives are always moving.
“Somebody is having baby, getting married, divorced or just wants to downsize,” she says. “We help them all to find the right home.”
For more strategies on how to be successful with listings, watch the webinar
“Listings: Now & The Future” presented by James Ellis at CRS.com/webinars
REEVALUATE YOUR MARKETING SPEND
Regardless of your lead generation tactics, CRSs say that this market shift is an ideal time to take a closer look at your marketing activities.
“If you’re not looking at the bottom line and really understanding what’s working in your marketing, you’ll want to reevaluate that right now,” says Sven Andersen, CRS, CEO of Andersen Group Realty in Winchester, Massachusetts. Andersen has a hard-and-fast tactic:
He closes out all recurring marketing expenses every year and then cherry picks only the ones that are working to resurrect.
Meanwhile, others are looking at their ad spend on listing sites.
“Those have absolutely slowed down, so I’ve decreased how much I’m buying from them,” says Donna Jones Craig, CRS, broker with Jim Maloof Realtor in the Peoria, Illinois area. “The ROI is just different now; I’d rather put it back into my database.”

Residential Real Estate Council crs.com JAN/FEB 2023 25
iStock.com/Mary Ne/kali9/undefined undefined
4
RECESS THE
By Shaila Wunderlich
With its perfect storm of record-low property values and record-high unemployment, The Great Recession of 2008 triggered a rash of residential short sales.

And a generation of REALTORS® skilled at executing them. The distressed-sale transactions allowed homes to be sold for less than their owed mortgage balance, providing millions of homeowners the best and only alternative to losing their homes to

foreclosure. “These were people who found themselves in a very serious situation, and needed help getting through it, and help not getting taken advantage of,” says Steve Fiorella, CRS, associate broker with RE/MAX Results in Minneapolis, Minnesota.

The Residential Specialist trsmag.com JAN/FEB 2023 26
iStock.com/Tatiana Stepanishcheva/Scar1984
ION-ERA

Training was trial-by-fire, as real estate, banking and mortgage professionals tackled the unprecedented scenario with little to no experience.

By 2009, when the Minneapolis Area Association of REALTORS® (MAAR) was tracking one short sale for every 10 traditional sales, Fiorella and his colleagues had emerged as experts in the niche transaction. “My first short-sale listing was in fall 2007,” says Addie Owens, CRS,
principal broker with Touchstone Real Estate in Florida’s Lake and Sumter Counties. “Within three months, I had about 30 listings.”
Fifteen years later, short sales have practically vanished from public and professional consciousness. Commencing their decline in 2013, the transactions have dwindled from an 11% peak in 2008 to a mere 1% of all present-day home sales, according to Zillow. “In many parts of the country, anyone who’s been in real estate less than five years only knows a white-hot market,” Fiorella says.
Fiorella hasn’t forgotten, nor have any of his seasoned peers. Collectively, their recession-era experience represents a vast residual brain trust in the discipline of short sales. And while no one knows when (if ever) real estate will suffer another short-sale episode, history suggests it could occur without warning. A calm, healthy market may be the ideal environment to lean into the learnings provided by these experienced short sale experts.
Residential Real
crs.com JAN/FEB 2023 27
Estate Council
Deal breakers for agents
Asked for advice on breaking into short sales, the experts consulted for this article were unanimous on two key points.
❶ Short sales are not suited to all REALTORS ® .
❷ Thorough education and preparation are essential prior to taking on a distressed property sale.
The pair of cornerstone statements suggest a central takeaway, which is that the business of short sales should be undertaken deliberately, with full knowledge of the pros and cons, and a total commitment to learning. “The thing about short sales is
if you make a mistake, your client can end up in foreclosure,” says Carol Moson, CRS, REALTOR® and associate broker for RE/ MAX Around Atlanta in Atlanta, Georgia. One-fourth of Moson’s portfolio comprised short sales during the recession years.
what are the pros and cons of short sales?
CONS: The downsides to short sales are numerous, ranging from the high stakes mentioned by Moson to the endless paperwork to the unpredictable and drawn-out timeframes. A typical short sale can take anywhere from three months to several years, depending on an agent’s expertise and the efficiency of paperwork processing. “With larger lenders especially, any time something is submitted late or incorrectly, it goes back to the bottom of the pile,” Fiorella says. “It can feel like starting from scratch.”
Check out the webinar recording “Best Tips for Top Notch Short Sale Negotiations” at CRS.com/ recordings
PROS:
There’s something to be said for owning a specialized skill—especially when the skill becomes suddenly in-demand—but for most short-sale stalwarts, the “why” usually comes down to helping people out of desperate situations. “The homeowner avoids foreclosure, so the impact on their credit is not as severe, and typically they can purchase another home in less time than is permitted after a foreclosure,” Moson says.
“There’s nothing more humbling than sitting across the dinner table from a couple losing their home,” Owens says. “There’s also nothing more rewarding than selling those same people houses later. Watching them recover financially—those closings were the sweetest.”
It’s worth noting that short-sale commissions are usually comparable to traditional listings. “It was regularly reduced by the lender, but I always charged the same fee,” Owens says.
Bowing out or forging ahead
When the cons outweigh the pros, Moson and Fiorella suggest handing the sale off to another, experienced agent in exchange for a referral fee. That applies to both new listings as well as those in-process. “If I hit a point where I become unsure, I’ll seek out someone with more experience or hand it off to another agent,” Fiorella says. “I’m not too proud to say if I’m in over my head.”
If, on the other hand, short sales seem a good fit, it’s time to get educated. Continuing education courses arm REALTORS® with knowledge to execute the job and accreditations to attract the clients. Examples include
Certified Distressed Property Expert (CDPE) and Short Sales and Foreclosure Resource (SFR), which Moson earned just before the crash of 2007. “I felt it would be a source of business but also critical toward educating myself.”
Next, seek out colleagues seasoned in short sales for possible mentorship opportunities. Moson mentored and assisted fellow agents both personally and professionally, as an instructor of a course on short sales. Owens did, as well. “I’m an open book when it comes to any agent asking who and how,” she says.
The Residential Specialist trsmag.com JAN/FEB 2023 28
Potential pitfalls

Most short-sale mistakes occur as the result of REALTORS® not being fully aware, from the outset, of all parties’ requirements.

The documents The financials The right understanding The “fake” offers
Topping that list are the many documents, instructions and deadlines set forth by lenders as part of their short sale “packaging” parameters. “Every bank is different, and they don’t necessarily spell it out for you unless you ask,” Fiorella says. “Each time you overlook a step or incorrectly submit a form, it can set you back weeks—or sink the deal entirely.”
Trying to communicate with the lender without the homeowner’s permission is one example of a packaging pitfall. “The homeowner must fill out a form stating you have permission to help facilitate on their behalf,” Moson says.
Another common mistake is not properly vetting a homeowner’s financial status. Homeowners must meet certain hardship criteria to qualify for a short sale.
REALTORS ® can wait for the bank to complete their audit (and risk rejection halfway through the process) or they can collect the information themselves, as early as possible. “For every homeowner who fell onto hard times after a serious medical condition or job loss, there often was another who had simply gotten underwater on their loan and was trying to take advantage of the situation,” Fiorella says.
Once the lender approves a short sale, agents must be hyper vigilant of all subsequent communications. “Common practice among lenders back then was to send out a letter saying, ‘Congratulations, homeowner, here is your lien release,’” Fiorella says. “To the untrained eye, that letter could be mistaken for full satisfaction of the loan.”
In reality, a lien release simply frees the property to be sold. Successful short sales procure a “full release and satisfaction of mortgage,” which not only releases the lien but also declares all debt satisfied and paid in full. This full release must be secured in writing and prevents the lender from seeking future payment from the seller. “If you don’t know what you’re reading, it can be misleading,” Moson says.
Of a more unscrupulous nature are offers to take over an approved short sale. “These are thirdparty companies who reach out to REALTORS ® and offer to take over the file for a fee,” Moson says. “Some of them are frauds; they take the fee and never perform the service. And even in the cases where the company is legitimate, the fees can be hefty.”
Thankfully, most of these mistakes can be avoided with a proactive investment of homework and preparation before the transaction begins. “I can’t stress enough how important it is to immediately connect with lenders, both to learn their specific protocols and establish a relationship,”
Fiorella says. “It saves so much time and mitigates a lot of risk.”
“Keep up with industry expectations and potential pitfalls,” Owens says. “If the lender asks for something 50 times, give it to them 52 times and keep records of it. Organization is your best tool.”
Residential Real Estate Council crs.com JAN/FEB 2023 29 iStock.com/LysenkoAlexander/mikkelwilliam

The Residential Specialist trsmag.com JAN/FEB 2023 30 iStock.com/
homes with a TROUBLED PAST
By Regina Ludes
“Elsie” Foster, CRS,
Sylvia
president of Foster Realty in Waianae, Hawaii, has seen her fair share of problem homes.
These include everything from former drug houses to homes that were the site of suicides and murders. She recalls one particular home in her area where an off-duty prison guard killed his mother in the garage.
“Several months after the incident, the family approached me about listing the home, but I turned it down. Several years later, it came back to me as a real-estate owned (REO) property,” recalls Foster. After the bank appraised the property and priced it accordingly, the home eventually was sold to an owner-occupant for roughly $60,000 less than the market rate at that time.

Residential Real Estate Council crs.com JAN/FEB 2023 31 iStock.com/ASphotowed/leolintang/VikiVector
According to Realtor.com, 20% of Americans said they would be willing to live in a home where a murder took place. Another 17% said they would live in a home believed to be haunted, while 46% would live in the haunted home if it was purchased at a discount.
Most people are turned off by the thought of living in a home believed to be occupied by ghosts or where a murder has taken place. However, in markets with limited inventory, stigmatized homes
are drawing interested buyers who are willing to overlook their sordid past in the hopes of snagging a deep discount. Stigmatized homes present a unique challenge for agents who must overcome negative public perceptions about the property to reach the right buyer. By focusing on positive aspects of the property and properly disclosing past negative events, CRSs can succeed in finding suitable buyers for stigmatized homes.
WHAT’S SCARIER THAN OWNING A HAUNTED HOUSE?
According to Realtor.com, only 5% of Americans say ghosts are the scariest aspect of homeownership. Other things are scarier, including:

Association
®
marketing stigmatized homes
Those negative events could be a violent death, suicide, drug house, alleged hauntings or a notorious previous owner. Even the home’s location near a murder house or cemetery can make it stigmatized. The majority of stigmatized properties Foster has dealt with were previous drug houses that became REO properties. Foster says they often smelled and had suffered serious damage. “In some cases, the homes were in such poor condition, I would white box them—remove appliances and fixtures, give it a fresh coat of paint, remove the smell and show only the slab and white walls. That way buyers could do whatever they wanted with it,” she explains.
Foster says stigmatized homes don’t stay on the market long in her area because inventory in Hawaii is so low. Investors are snatching up properties almost as soon as they become available. “The worse a property is, the more buyers seem to want it,” Foster says.
Though she is not required by state law to disclose the home’s stigmatized history,



Foster says she discloses the information anyway, even in the case of a natural death. “A stigmatized home is a material fact because it can affect the value of the property,” she explains.
Most states do not require disclosure of events that stigmatized a property.
f In California , agents must disclose if a death occurred in the home within the past three years .
f In Alaska and South Dakota , they must disclose if the event took place within the past year.
f In New Jersey , disclosure is required if the death was connected to some physical condition of the home, such as a collapsed roof which killed the occupant.


The
Specialist trsmag.com JAN/FEB 2023 32 iStock.com/D-Keine/Shaun
Residential
Lowe/Francesco Scatena/Tomas Ragina/xjbxjhxm
Americans would rather purchase a haunted house than live:
The National
of REALTORS
defines a stigmatized property as: “A property that has been psychologically impacted by a negative event that occurred on the site that left no visible evidence that it occurred.”
CA ND NJ AK
Source: 2021 Realtor.com survey
57 %
56 % 48 % Within one mile
47% Near the
45 % Near a meth lab 44 % Within one
50% 40% 30% 20% 10% 0
Mold
Foundation issues
of a waste management facility
scene of a violent crime
mile of a prison
54
Pests (termites, cockroaches), asbestos, water damage
%
disclose discreetly
Only once in her 45-year real estate career did Jane Fairall, CRS, associate broker with Palmer House Properties in Atlanta, Georgia, have to deal with a stigmatized property. At the time, she was the managing broker for another real estate company when a seller approached one of her agents about listing the home.
“When the seller informed my agent that there had been a suicide in the basement within the past year, she came to me for advice. I didn’t know what to do. It was not required to be disclosed, and I had never encountered anything like that before,” recalls Fairall. “I knew from my experience, though, that if you don’t disclose something, people will find out about it anyway.”
After meeting with the seller and the rest of her team, Fairall decided not to disclose the event until a buyer’s agent approached them about the house. Not long after that, the first interested buyer came along. Fairall discreetly shared the home’s history with the buyer’s agent, who discussed it with the buyer. The buyer did not have a problem with the suicide, and
the house closed quickly at the market rate, Fairall says.
“It’s better to disclose those details up front because otherwise someone else could tell the buyer what happened,” Fairall says. “I would handle the situation the same way today.”
address rumors
Sometimes, superstitions and rumors of untimely deaths can give a house a bad reputation. Agents should be prepared to address those concerns.

In Hawaii, when rumors circulated that a condo unit she was renting out for a client was haunted, Foster brought in a kahuna, or Hawaiian priest, who confirmed there were no spirits living there and performed a blessing. Once neighbors saw this blessing, it stopped the rumors, Foster says.
Fairall says when dealing with rumors, she does not acknowledge them either way. “If the buyer or their agent have concerns about a certain property, I advise them to search news articles, the internet and death records to find out if there’s any truth to the rumors,” she advises.
Want more listings? Learn what top agents do to win more listings in the course “Creating Listing Abundance” at CRS.com
focus on the positive
Even with a troubled past, stigmatized homes have some features that can be presented in a positive light. Though Foster’s stigmatized home was located off the main highway, it came with an upstairs balcony that provided a perfect, unobstructed view of the ocean. Likewise, if a drug house had been gutted, Foster helps buyers envision how they can make it their own.
Fairall takes a different approach by mentioning the negatives up front. “If you mention a negative aspect of the house
before showing it, usually people will minimize it. They might say afterward, ‘Oh, that’s not so bad.’”
She has this advice for agents: “Get all the facts from the seller. Consult with your broker, then make sure everyone agrees on a strategy to market the house. If the seller doesn’t want to disclose the incident, you always have the option of not taking the listing.”
With the right marketing strategy and proper disclosure, agents can give stigmatized homes a fresh start.
Residential Real Estate Council crs.com JAN/FEB 2023 33 iStock.com/ASphotowed/SolStock
The Residential Specialist trsmag.com JAN/FEB 2023 34 iStock.com/Mr.CO711 Market Values Insights from industry data ALL RESPONDENTS 2022 APPRAISAL Do you feel there are delays in your market in completing appraisals? What is the typical wait time in days to receive a completed appraisal report from a lender? What is the typical cost in U.S. dollars for an appraisal in your local market? ■ Yes ■ No ■ Don't know ■ 1–5 ■ 6–10 ■ 11–20 ■ 21–30 ■ More than 30 ■
■ $300
■
■
■
■
■
Appraisers are more likely than others to cite sex discrimination and to simply say they have not witnessed it. 1% — Religion 1% — Sex 1% — Handicap 1% — Familial status (including marriage or parental status) 1% — National origin 1% — Sexual orientation Have you ever witnessed or experienced discrimination in an appraisal based on any of the following? 5% — Not sure 2% — Color 2% — Race 16 % — No, but I believe discrimination in appraisals exists 77% NO 19% 35% 46% 36% 28% 20% 12% 4% 30% 22% 19% 9% 7% 6% 7%
Less than $300
to $399
$400 to $499
$500 to $599
$600 to $699
$700 to $799
$800 or more
Residential Real Estate Council crs.com JAN/FEB 2023 35 For more information,
Source: NAR SURVEY Thoughts from randomlyselected appraisers and non-appraiser NAR members. APPRAISERS Have you ever conducted a valuation of a home through... How often are you asked to conduct appraisals outside of your geographical or property type expertise? NON-APPRAISERS Have you ever had a transaction fall through because of an appraisal? What was/were the reason(s) the transaction(s) fell through as a result of an appraisal? (Top 5) How many appraisers do you personally know? ■ In-person appraisal ■ Desktop/drive-by appraisal (appraiser did not enter home) ■ Evaluation (non-appraisal: opinion of value) ■ Automated valuation model (AVM) ■ Other appraisal method 18% Daily Weekly Monthly Once every 6 months Rarely/never 31% 17 % 11% 23% 54% OF APPRAISERS FEEL FAIRLY COMPENSATED FOR EACH APPRAISAL. 40% DO NOT FEEL FAIRLY COMPENSATED. ■ Yes ■ No ■ Don't know Appraised value Appraiser lack of knowledge/ use of inappropriate comps Buyer unable to cover gap Seller refusal to adjust price Need for repairs 74% 39% 35% 34% 17 % ■ None ■ 1–5 ■ More than 5 40% OFTEN USE A LOCAL APPRAISER. 44% SAY MOST OR ALL OF THEIR CLIENTS DO NOT UNDERSTAND WHAT AN APPRAISAL GAP IS. 97% 79% 11% 8% 7% 47% 47% 5% 57% 32% 11%
access the 2022 NAR Appraisal Survey at NAR.realtor
Brian Copeland, CRS, is the founder and CEO of Doorbell Real Estate in Nashville, Tennessee. He has appeared on numerous shows on HGTV and The Learning Channel and served as one of Facebook’s Global Community Leadership Council members. He has been one of the most sought-after real estate speakers and consultants in the country, emceeing and keynoting some of the largest conferences in the industry.
Building Your Brand
 By Brian Copeland, CRS
By Brian Copeland, CRS

When you think about how to build your personal brand, it’s good to go examine important relationships in your life. We have our spousal relationships, our friend relationships and relationships with our children, which are essential to our lives. And as REALTORS®, one of our most important relationships is with our own community or city. In my case, people have always known me as having a huge love affair with Nashville, Tennessee, and so I’m known as Nashville Brian.
In the class I am leading for RRC, “Building a Personal Brand,” we will go over what a successful brand is—and what it is not. Your brand is a feeling that people get about you. Not the logos, graphics, videos or TikToks that you’re putting out. Those are promotional pieces. When someone says your name, what do they think? Is it joy, lemonade and bubble gum, or prickly pears and vinegar? Are you a “yes” or a “no” brand? When someone says your name or your team’s name, is it a brand of “yes” for a consumer and your fellow REALTORS ®?
Another way to think about your brand is what it attracts versus what it repels. In online communications especially, you should look at everything you do and say, and think: Is this post going to endear people to me or is it going to push them further away? Examine your content and think, “Who could be left out of this post? If I’m joking or saying something very specific about a holiday, who am I excluding in that?” Make sure your brand is inclusive.
Avoiding common branding mistakes
I mentioned earlier that your logo, graphics and color choices were part of your promotional materials, not the brand itself. But they must support your brand
The Residential Specialist trsmag.com JAN/FEB 2023 36 iStock.com/ Council Classroom
educators SPECIALIZED KNOWLEDGE iStock.com/DrAfter123
Strategies from the industry’s top
identity. You need to be very cognizant of the fonts, the colors, the simplicity versus the busyness of your brand. I believe that less is more attractive in branding pieces. I frequently see real estate branding that is just all over the place. There are so many fonts, so many words, so many graphics, so many colors—and that’s a huge mistake.
Other areas to avoid include discussing politics or religion. You can argue and say, “Hey, I want to attract this demographic,” but I would say that you need to be careful that you’re not violating Fair Housing standards. If you’re trying to attract only one demographic, you’re repelling other demographics, in turn setting yourself up for liability lawsuits when it comes to Fair Housing.
Be authentic and harmonize your brand
I believe in omnipresent branding, which means you always present yourself in the same way in all places—or at least it seems that way to people. When you’re omnipresent in your branding, you’re sharing your business, you’re sharing your personal life (within certain limits) and they’re all in harmony. It goes back to your brand: What do you want to be known as? Do you want to be known as the serious businessperson? Do you want to be known as the fun person that everyone wants to spend time with?
I see a lot of people online and unfortunately, they’re very unclear on what they want to be. One day, they’re upset about something. The next day, they’re excited about having lots of closings. Then they’re going off about some political thing, and the day after that, they’re depressed their parents did not treat them properly during their last visit. You must learn the difference between being authentic and over-sharing.
The consumer cannot get to know you unless you open your brand to them. And that brand can be many, many things, but it needs to be focused. The more you’re focused on that brand, the more you’re going to attract the consumer that will ultimately make you the happiest. That’s why proper branding is essential.
You can follow and connect with Brian Copeland, CRS, on Instagram and Twitter at @nashvilleBrian
Residential Real Estate Council crs.com JAN/FEB 2023 37
When someone says your name or your team’s name, is it a brand of ‘yes’ for a consumer and your fellow REALTORS®?”
—Brian Copeland, CRS
Content is essential for marketing yourself, your business and your latest listings. Learn how to create a strategy with the new webinar “Creating a Content Gameplan for 2023” at CRS. com/webinars
Marketing Ideas to Stay Top of Mind
As we begin the new year, it’s important to have a marketing gameplan in place to increase your chances of success.

How are you staying connected with past clients? With a new year comes new homeownership goals for many—with the
proper marketing and outreach, you can position yourself to be the agent your clients return to as they set out to accomplish their 2023 resolutions.
Here are a few ways our CRS agents are reconnecting with their clientele and staying top of mind in 2023.
1 . Handwritten notes and postcards
In a time where everyone seems to communicate through technology, a handwritten note can go a long way.
“[I] still do monthly snail mail—it 100% still works,” says Linda Price, CRS, broker associate with RE/MAX of Naperville in Naperville, Illinois. “My clients know by the third week of the month they’re going to get something from me.”
Alexis Bolin, CRS, broker associate with Keller Williams Realty Gulf Coast in Pensacola, Florida, and Cherie Benoit, CRS, sales agent with Keller Williams Realty Pinnacle Central in Worcester, Massachusetts, have found success mailing out postcards with their favorite recipes and household tips.

2. Monthly planners and calendars
2
Maria Dargan, CRS, broker associate with RE/MAX Revolution in Lanoka Harbor, New Jersey, opts for a yearly calendar magnet. “Each year, I send magnetic calendars so clients can place them on their refrigerator—they get to see me every day!”
Be sure to highlight important holidays or any events you might host throughout the year.
The Residential Specialist trsmag.com JAN/FEB 2023 38 Marketing Matters Timely advice to promote your business SPECIALIZED KNOWLEDGE iStock.com/Enis
Aksoy/lillaelapo/Kunakorn Rassadornyindee
1
3. Magazine subscription and newsletters

By sending your clients a personalized newsletter or industry magazine, you’re not only staying top of mind, but you’re also providing them with valuable industry insights they can utilize in their day-to-day life.
Kristie Tindall, CRS, managing broker with Brinkoetter Realtors in Decatur, Illinois, likes to send her base clients the monthly customizable “Your Home” newsletter—a benefit offered to all RRC members. She also sends Reminder Media Magazine to select, long-standing clients.
4. Don’t underestimate social media
When it comes to staying connected, Melissa Lundgren, CRS, broker associate at Better Homes & Gardens-Leaskou Partners in Palm Springs, California, has a favorite method: “Facebook, Facebook, Facebook!” Why does she use Facebook as her go-to marketing tool? Because it’s free.

“Friend them, pay attention to them, connect, engage, like, comment, tag, repeat,” Lundgren advises. The simple act of liking or commenting on a client’s post will get them thinking about you in no time.
5. Pop by with a pie

Patricia Gaskin, CRS, broker associate with C/21 Rl Est Champions in Madeira Beach, Florida, says clients remember her for her pies.
“The best response [I get] is when I personally stop by and deliver a pie of their choice,” says Gaskin. “It’s a chance to stop in for a quick chat or coffee and catch up.”
Food is a universal love language. If you have the time, think about delivering your preferred treat around your neighborhood. This offers your clients the chance to, quite literally, open the door to you once more.
6. Give the gift of email
After not seeing success in his email campaigns, John Young, CRS, sales agent with RE/MAX Excellence Realty in Silver Springs, Maryland, switched up his methods. He now sends out unique emails that offer something of value to his clients which gets his inbox blowing up.
“I realized that ‘Happy Anniversary’ email didn’t really produce engagement,” says Young. “When I started offering something of value, it got my phone ringing.”
For example, when the first freeze warning is announced in his area, he puts out an email to previous clients offering to bring by hose bib covers and install them.
He calls this the “Law of Reciprocity”—if you offer something of value to someone, they feel compelled to give you something back.

Residential Real Estate Council crs.com JAN/FEB 2023 39 iStock.com/panida wijitpanya/Liudmila Chernetska/billdoss
3 4 5 6
Recognizing the 2022 RRC Award Recipients
The Council distributes awards each year to members and State RRCs that make outstanding contributions to the Council, their CRS designee peers and the real estate industry. Here are this year’s recipients:

f For more information about the RRC Awards program, visit CRS.com/ about-us/ leadership/ RRC-awards
Education Contributors of the Year Award
This award recognizes those individuals who have provided significant contributions to RRC in the education of professionals in the field of residential real estate.
Frank Serio, CRS


Kathleen Ryan, CRS



State/Region RRC Spirit Award
This award is presented to the state/region that completed their activity plans and increased member engagement and networking in the most creative way.
Idaho RRC
State/Region Membership Growth Award
This award is presented to the state that exhibited the largest percentage of growth over a 12-month period.
Idaho RRC
Lifetime Achievement Award
This award is given to an individual for their outstanding and sustained contributions to the Council and residential real estate industry.
Lee Barrett, CRS


State Leaders of the Year Award

This award is presented to state leaders who demonstrated outstanding contributions in the last twelve months.
Teresa Bidez, CRS (Georgia) Tamara Towns-Pozorski, CRS (Wisconsin)
President’s Award
This award is presented to individuals who provide assistance to the president during their term.
The Residential Specialist trsmag.com JAN/FEB 2023 40
Lee Barrett, CRS
Teresa Bidez, CRS
Tamara TownsPozorski, CRS
Frank Serio, CRS
Kathleen Ryan, CRS
Alex Milshteyn, CRS
Joshua Woodward, CRS Keith Tristano
Alex Milshteyn, CRS
Kieth Tristano
Joshua Woodward, CRS
RRC Members Continue to Support RPAC




“The level of commitment that the RRC leadership team, our CEO, Board of Directors, designees and members have for the future of this industry can not be overlooked,” says Holli Woodward, CRS, 2022 RRC president. “The RPAC numbers speak for themselves. As a token of gratitude and recognition, Mark Shepherd, CRS, and I created the first CRS RPAC Major Investor pin. They are now proudly worn across the country. And for the first time in the Council’s history, every member of the leadership team, including our CEO, is an RPAC Major Investor President’s Circle member. Our entire Board of Directors, with the exception of our outside director, are also RPAC Major Investors. We are
invested and committed—the Council’s future is bright!”
“RRC has so many attributes that bring pride of membership and affiliation,” says Jeff Hornberger, CEO of RRC. “Our members’ supersized participation in RPAC at all levels is yet another constellation that positions our members as the gold standard of residential real estate.”
RRC Board of Directors at the NAR NXT event in November 2022.
Residential Real Estate Council crs.com iStock.com/adamkaz
To learn more about RPAC, s can the QR code below!
2023
RRC RPAC Participation (as of Nov. 30, 2022) Total Invested: $4,528,452 Average Investment: $358 ■ Major Investors: 2,249 ■ President’s Circle Members: 652 60 % of all CRSs invest in RPAC.
Call past clients. Ask them how they are doing and let them know that you are still in business.

David Anderson, CRS, RE/MAX of Pueblo Inc., Pueblo, Colorado
What’s everyone doing to keep new business coming in?
It’s time to get back to basics. Have a personal talk with everyone in your database just to catch up on old times. Take some classes on negotiation, scripts and dialogues, as these are the skills we must be proficient in when we have a change in market.
Alexis Bolin, CRS, Keller Williams Realty Gulf Coast, Pensacola, Florida
Looking forward with joy, knowing I’m the best for my clients. And knowing from experience this will pass. [I’m] continuing to build relationships, knowing others will retreat.
Nellie Arrington, CRS, Long & Foster Real Estate, Inc., Columbia, Maryland
First, don’t panic. The market always has its cycles. In a downturn, it’s always best to go back to basics. Try good, old-fashioned prospecting, learn about financing (buydowns and ARMs are two in particular), or bone up on the mortgage interest deductions. Continually take classes. Don’t portray doom and gloom, just understand the market. You’ve got this.
Peter West, CRS, Bishop West Real Estate, Venice, Florida
I’m relaxing, taking care of myself and waiting this market out.
Joy Dillon, CRS, Mary Begier Realty, Hilo, Hawaii
Some of us just had the extra wallop of a hurricane. Many of us have focused on simply helping in our affected communities. It helps to stay focused on the needs of others. If it’s from the heart, it can create authentic connections for future business, too. Create or host your own community or business events with local small businesses and use them as fundraisers to help the local food bank or other organizations. ‘Tis the season for fundraising for many organizations.
Christine Williams, CRS, Florida Homes Realty & Mortgage, Jacksonville, Florida
Have a great story to share? Email social@crs.com or look for discussions happening online on our Facebook, Instagram, LinkedIn and Twitter pages.
I began beefing up marketing efforts for the entire team and dipped into reserves (calls, notes, face-to-face, client events monthly, pop bys), and slowly we are seeing our efforts pay off. We have two additional events in the next 18 days (happy hour and “yappy” hour). Don’t panic—power through.
Kim Cameron, CRS, Better Homes & Gardens Real Estate Preferred Properties, St. Louis, Missouri
The Residential Specialist trsmag.com JAN/FEB 2023 42 Ask a CRS Advice from your peers
& DESIGNATION NATION
Q
iStock.com/Deepak
Sethi/Olga Strelnikova/Alex_Bond

Experience these new features at find.crs.com or via the mobile app. VISIT THE NEW FIND A CRS LOOKING FOR MORE WAYS TO EXPAND YOUR NETWORK AND GROW YOUR REFERRALS? Connect with the best, and download the newly enhanced Find a CRS* *Available on the App Store or Google Play NEW EXCITING ENHANCEMENTS INCLUDE: Badges that Encourage and Reward In-App Communications Build Your Network, and Build Up Each Other A Greater Sense of Community and MORE! Live News Feeds at Your Fingertips
CONNECTION PERFECTION
An All-CRS Affair
With my recent listing, I knew that I was in for a pleasant transaction if we ended up having Judy Chin as a fellow CRS agent on the buyer’s side. It started with a complete, well-presented package on behalf of her buyer, and added to it a competent and confident loan officer who had done a thorough vetting.
The presentation was a sign that we were working with somebody with experience and professionalism. When I presented the offer to my seller, I knew it would be as smooth a deal as possible given the fact we knew who we would be working with if they decided to choose this offer.
Michele Chiles-Hickman, CRS, Berkshire Hathaway HomeService, Montclair, New Jersey

Once Michele relayed the good news that the sellers accepted my client’s offer, I knew the process would be straightforward all the way until closing. I was able to explain to my clients that a seasoned CRS was representing the homeowners. That was very important for this home sale since there were various hurdles to get over—all of which were handled with superior professionalism and follow-through. Working with a CRS meant your calls, texts and emails were returned in a timely manner.
Everyone exercised the highest level of integrity throughout the transaction. Despite the expedited closing timeline sprinkled with unexpected challenges, we ensured closing remained on schedule.
Judy Chin, CRS, RE/MAX Villa, Edgerwater, New Jersey

The Residential Specialist trsmag.com JAN/FEB 2023 44 iStock.com/crossroadscreative RRC Connect Expand your network
DESIGNATION NATION
Judy Chin, CRS
Michele ChilesHickman, CRS
Montclair
Edgerwater
NJ














Residential Real Estate Council crs.com 45 YOUR ALASKAN REAL ESTATE SOLUTION IN ONE PLACE. LEVEL UP YOUR NETWORK. JOIN OUR FACEBOOK. SHARLI ARNTZEN Associate Broker, REALTOR CRS y SCAN HERE AND JOIN FOR FREE. MAUI Real Estate www.JoanneFoxxe.com 808-385-2918 jofoxxe@gmail.com oanne oxxe SRES e-pro director Keller Williams Maui Luxury Real Estate Kapalua Lahaina, HI 96761 Joanne Foxxe CRS, GRI, SRES, e-Pro, RSPS 808-385-2918 cell and direct line Search all Maui properties on my website www.JoanneFoxxe.com Quality isn’t expensive, it is priceless. Top 100 Hawaii Realtors 2017. Oh by the way, I am never too busy for your referrals. MAUI PACIFIC PACIFIC PACIFIC NORTHWEST MID-ATLANTIC WEST Terry Young 773.213.9161 terryyoung@remaxnext.com www.terryyoungproperties.com Accomplished REALTOR® representing buyers and sellers in Chicago and surrounding areas for 20+ years. MIDWEST Contact Joe Stella: joe.stella@glcdelivers.com or 847-205-3127 Reach more than 30,000 CRS peers with your ad here.
The Benefits of Setting Aside Time for Reading
According to a 2021 survey by the Pew Research Center, 23% of American adults shared they had not read a book, in part or in whole, in any format, in the past year. When’s the last time you read a book? If it’s been a while, consider changing that. Setting aside time to read on a
regular basis is important for both your mental and physical wellbeing. In 2016, Yale researchers found that those who read more than 3.5 hours weekly were more likely to live longer than nonreaders. Here are 5 more reasons why you should incorporate reading into your routine.
Helps avoid cognitive decline
Your brain may not be a muscle, but it still needs a healthy dose of exercise to function well. Reading is a great way to exercise your mind, strengthening your neural paths and networks as your reading abilities mature. The National Institute on Aging recommends reading to keep your mind engaged as you age.
A form of entertainment
Give your eyes a break from the TV, phone and tablet screens. A good book can transport you into a whole new world. It’s one of the oldest forms of entertainment, and it’s still free. Visit your local library and choose an escape.
Increases ability to be empathetic Fiction stories examine and probe the interpersonal relationships and personalities of characters.
Researchers have found that people who read fiction tend to have a more advanced ability to be empathic to those around them.
Builds your vocabulary
Researchers have found that those who read more tend to have more expansive vocabularies. Having a wide vocabulary will broaden your creativity, improve your comprehension and positively impact your professional prospects.
Helps you sleep at night
Reading can be a great form of stress relief and many doctors recommend it as part of one’s regular sleep routine. If you tend to have trouble sleeping, you should try reading in a place other than your bedroom. Keep in mind that a print book will help you to unwind more than reading on a screen.
The Residential Specialist trsmag.com JAN/FEB 2023 46 iStock.com/Yulya Bortulyova/Stefan_Alfonso/tomozina/-VICTOR-
Balancing Act Practical strategies for restoring balance DESIGNATION NATION
PHOTOFY is more than just another photo editing app, it’s A POWERFUL CONTENT CREATION TOOL that has everything you need to create beautiful, professional photos right from your mobile device, specific to your CRS DESIGNATION.

Easily
“I just discovered this feature and OMG I’m like a kid in the candy store. Thank you!”
~ Paul Fedyinch, CRS

“This is a great item of value for our members! Way to go creating these pieces.”


~ Lindsey Culver, CRS

YOUR
personalize graphics with your photo/logo and contact information; then share on your social media accounts. Also find pre-loaded, ready-toshare videos and graphics with suggested copy! www.CRS.com/photofy Themes include seasonal, holiday, listing, and more! SCAN TO: GET STARTED WITH PHOTOFY BUILD
BRAND AND BUSINESS with
Helpful Tips 1
The lasagna is best the next day because it has had a chance to set. Have extra sauce available for the leftovers because it tends to soak up sauce as it cools.
2
Be sure to cover lasagna noodles completely with sauce as you layer.
The noodles cook by using the sauce juice.
3
You can use ½ Italian sausage and ½ lean hamburger, and this is a very tasty mix.
4
You can use zucchini as a replacement for the wheat noodles— however, they have a high-water content, so be prepared for a more watery lasagna.
Taste of RRC Delicious recipes from RRC members
Homemade Lasagna and Sauce
By Michelle Checchini, CRS, Broker Owner of Chelle Realty Co., Ormond Beach, Florida
Iam a self-taught cook who learned from watching PBS in the late ‘80s with Julia Child, Graham Kerr and Jeff Smith. Love Italian food? You must try my homemade sauce and lasagna recipe. I created this sauce in the ‘90s and have enjoyed it ever since. It is really easy and delicious. The smell of it cook ing on the stove will make you hungry for a good Italian meal.

MOMA MIA’S TOMATO SAUCE
Ingredients
1 tablespoon olive oil
1 medium onion, diced 3 garlic cloves, minced
1 tablespoon oregano 2 teaspoons basil 1 teaspoon fennel ½ teaspoon salt ½ teaspoon pepper 29 oz. can tomato sauce 29 oz. can diced tomatoes (chunky sauce) OR 29 oz. can tomato purée (smooth sauce)
2 teaspoons sugar
¾ cup dry red wine
Instructions
Have a recipe with a story behind it you’d like to share? Email us at social@crs.com
Add 1 tablespoon of olive oil to a large pot on medium heat. Add onion and stir until translucent and brown. Add the wine, stir and keep lid off. Let the alcohol cook down for a few minutes. Add sauce, tomatoes or purée, garlic, oregano, basil, fennel, salt and pepper, and stir. Cover to cook for another few hours. Add sugar and get ready for a great, healthy Italian sauce.
L ASAGNA
Ingredients
11/4lbs. gourmet sirloin or any ground beef, chicken, turkey (optional) Moma Mia’s sauce
9 oz. package of oven-ready lasagna noodles 3 cups mozzarella cheese



1 cup ricotta cheese
Instructions
Heat meat in skillet until cooked and remove excess fat and/or water. Preheat oven to 350 degrees. Use a 9” x 14” baking dish and using a ladle, cover bottom of dish with sauce. Then, layer ingredients in this order: 4 noodles, ½ meat, two handfuls of mozzarella cheese, ladle of sauce, four noodles, ricotta cheese, four noodles, ladle of sauce, remainder of meat, two handfuls of mozzarella cheese, four noodles, ladle of sauce. Cover with aluminum foil to bake for 45 minutes. Remove from oven and use remainder of mozzarella cheese and more if you’d like to cover top of the lasagna. Put back in oven for 15 minutes or until cheese is browned to your liking. Let sit for 15 minutes before serving.
JAN/FEB 2023 48 The Residential Specialist trsmag.com DESIGNATION NATION
iStock.com/ALEAIMAGE/guru86
Serves 8 Serves 8
























 By Amelia Garza
By Shaila
By Regina Ludes
By Amelia Garza
By Shaila
By Regina Ludes
























 Alex Milshteyn, CRS
Alex Milshteyn, CRS




 By Caroline Heller
By Caroline Heller

By Brian Copeland, CRS
By Brian Copeland, CRS





















































